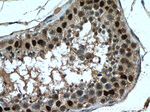
FTSJD2 Antibody in Immunohistochemistry (Paraffin) (IHC (P))
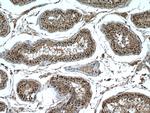
FTSJD2 Antibody in Immunohistochemistry (Paraffin) (IHC (P))

Search
Proteintech
FTSJD2 Polyclonal Antibody
{{$productOrderCtrl.translations['antibody.pdp.commerceCard.promotion.promotions']}}
{{$productOrderCtrl.translations['antibody.pdp.commerceCard.promotion.viewpromo']}}
{{$productOrderCtrl.translations['antibody.pdp.commerceCard.promotion.promocode']}}: {{promo.promoCode}} {{promo.promoTitle}} {{promo.promoDescription}}. {{$productOrderCtrl.translations['antibody.pdp.commerceCard.promotion.learnmore']}}
产品信息
27707-1-AP
种属反应
宿主/亚型
分类
类型
抗原
偶联物
形式
浓度
规格
纯化类型
保存液
内含物
保存条件
运输条件
靶标信息
S-adenosyl-L-methionine-dependent methyltransferase that mediates mRNA cap1 2'-O-ribose methylation to the 5'-cap structure of mRNAs. Methylates the ribose of the first nucleotide of a m(7)GpppG-capped mRNA and small nuclear RNA (snRNA) to produce m(7)GpppRm (cap1). Displays a preference for cap0 transcripts. Cap1 modification is linked to higher levels of translation. May be involved in the interferon response pathway. [UniProt]
仅用于科研。不用于诊断过程。未经明确授权不得转售。
篇参考文献 (0)
生物信息学
蛋白别名: Cap methyltransferase 1; Cap-specific mRNA (nucleoside-2'-O-)-methyltransferase 1; Cap1 2'O-ribose methyltransferase 1; FtsJ methyltransferase domain containing 2; FtsJ methyltransferase domain-containing protein 2; Interferon-stimulated gene 95 kDa protein; ISG95; KIAA0082; MTr1; S-adenosyl-L-methionine-dependent methyltransferase FTSJD2; unnamed protein product
基因别名: 1300018I05Rik; AI451264; CMTR1; FTSJD2; hMTr1; KIAA0082; mKIAA0082; MTR1
UniProt ID: (Human) Q8N1G2, (Mouse) Q9DBC3
Entrez Gene ID: (Human) 23070, (Mouse) 74157